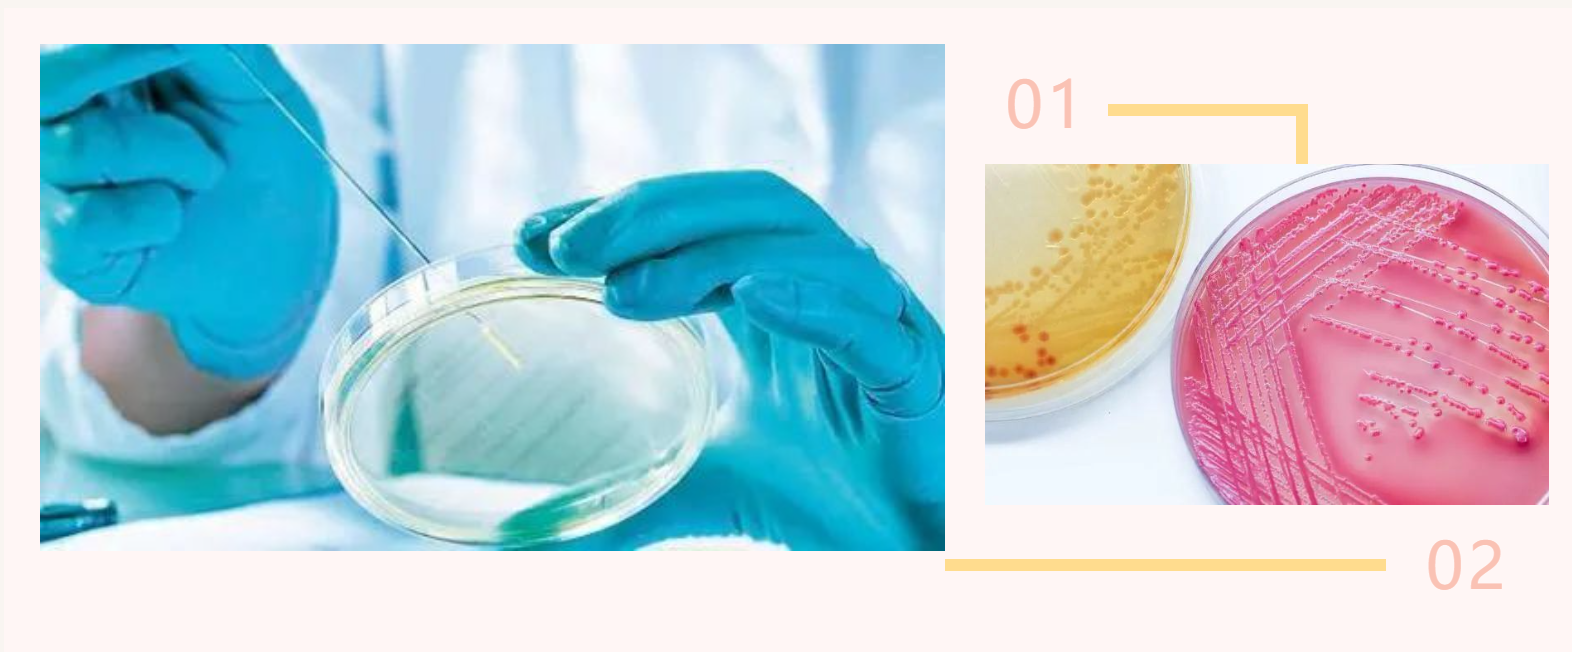
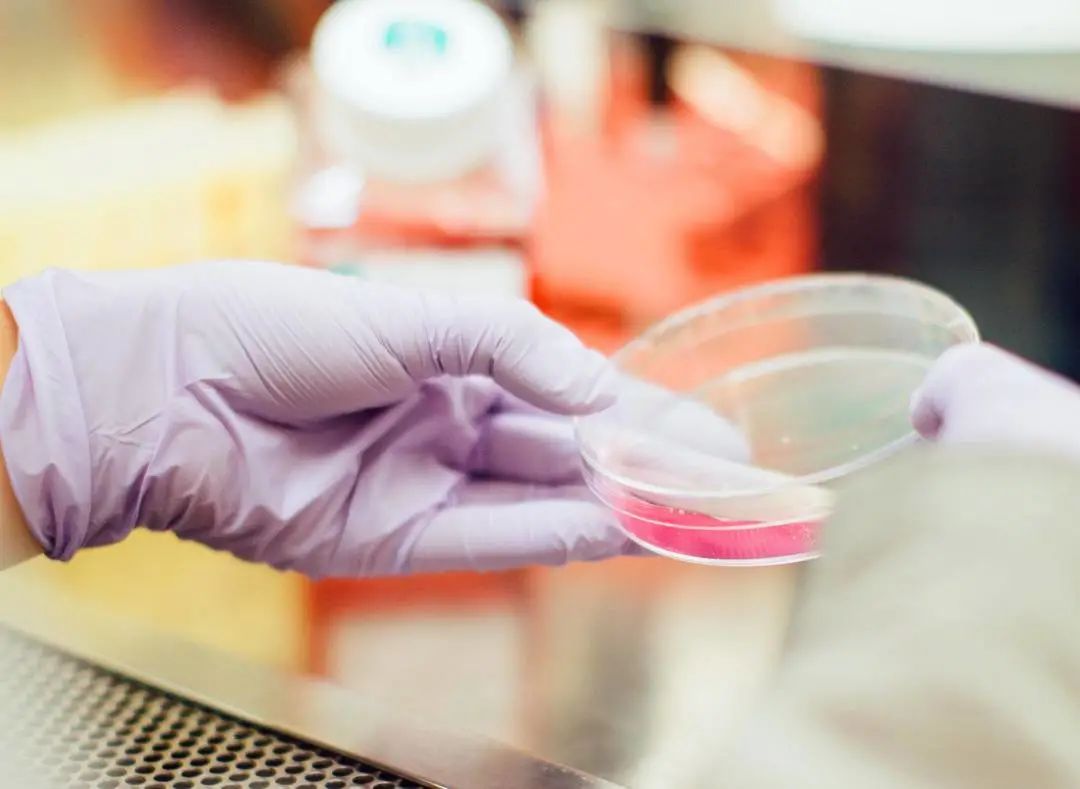
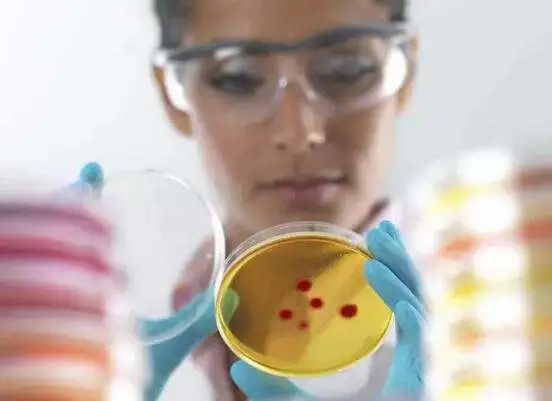

菌落总数测定结果误差大?原因都在这里↓↓↓
发布时间:2025-05-09 浏览次数:3984
在食品微生物检验过程中,测定菌落的总数可以分析菌落的繁殖和生长情况。随着食品安全问题的突出,检测结果准确无误也是确保食品安全的基石。但是,在食品菌落总数检测中数据不准确的现象时有发生,问题主要出在哪里呢?

菌落总数在我国大量产品标准中有明确的限量规定,其中在GB 4789.2-2016《食品安全国家 标准食品微生物学检验菌落总数测定》(以下简称GB4789.2)中就规定了食品中菌落总数的具体流程。
1 培养基温度对菌落总数计数结果的影响
细菌培养用琼脂的凝点通常为32~39℃。GB 4789.2中规定,平板计数琼脂培养基需冷却至46±1℃时才能用于倾注计数,该温度与其他国家标准的规定存在细微的差异,就比如美国FDABAM规定倾注时PCA琼脂温度为45±1℃。
在实际工作中,由于实验人员操作速度、培养基原料差异等因素影响,即使在水浴锅中冷却至46±1℃的培养基在具体实验过程中时常会出现部分凝固现象。因此,在具体检验工作中培养基温度的控制提供了较宽的安全范围,可行性值得进一步深入探讨。
2 操作时间对菌落总数计数结果的影响
为了保证技术结果能准确反映样品的污染状态,GB4789.2中指定使用的样品稀释液为不含糖源和氮源的磷酸盐缓冲液或生理盐水,通常认为细菌在这2种溶液中的数量短时间内不会发生显著性变化,而且在GB 4789.2未对从样品前处理到琼脂倾注完成的时间给出明确规定。
但是在食品样品中时常含有丰富的营养物质,当与磷酸盐缓冲液或生理盐水混合后会给微生物提供良好的生长环境。为防止菌落数在检验过程中发生显著性变化,美国FDABAM中规定从样品原始稀释到倾注过程应在15min内完成。
因此,也在提示GB4789.2方法中应对从样品前处理到琼脂倾注成的时间给出明确规定,以防止因检验过程造成的菌落计数结果显著性差异。
3 倾注体积对菌落总数计数结果的影响
PCA培养基是菌落总数计数方法的关键要素,在不同标准中的使用体积存在明显差异。GB4789.2中规定PCA培养基在每个直径为90mm的平皿中倾注体积为15~20mL,而美国FDABAM中规定PCA培养基的倾注体积为12~15mL/平皿。理论上,虽然PCA培养基使用量的增加会增加单位面积培养基的厚度,可对在培养过程中出现的蒸发现象起到良好的缓冲作用。
据实验研究显示12~20mL/平皿的培养基使用体积变化不会对测试菌种的计数结果产生显著性影响,这一结果为实验室培养基耗材的节省提供了良好的数据支持。
4 培养基品牌对菌落总数计数结果的影响
目前,我国GB4789.28中针对PCA培养基评价用的参考物质为TSA培养基,与其相比,只要3个标准菌种的生长率大于70%即为符合要求,但是通过实验选用不同品牌的培养基计数结果间也出现了显著性差异。
但是在GB4789系列标准中缺乏明确的质量要求,致使不同生产企业根据各自能力来选择、使用该类原料,导致培养基质量出现了一定差异。因此,我国急需研制规范的培养基参考物质和评价方法,对PCA培养基的质量进行规范。
鉴于菌落总数计数结果为评判食品质量是否合格的定量指标,其检测计数使用的方式方法也很同等重要。

传统的人工肉眼计数,不仅耗费人力和时间,而且采用肉眼观测计数也会影响其准确性。环凯研发的Smartcounter自动菌落计数仪广泛应用于食品饮料、乳制品行业、医院、化妆品、制药工业中的微生物实验室检测,适用于对微生物的菌落计数和结果保存记录和溯源,能够完成所有的菌落读数类型,Smartcounter用户操作界面简洁、易用,是现代微生物检测实验室先进和高效的菌落计数器。
环凯全自动菌落计数仪产品优势
1、采用4K真彩色高分辨率摄像装置及超低畸变光学镜头,在硬件上保证了实验数据结果的准确可靠;
2、采用开放式平台,抗外界光线干扰设计,直接放平皿计数、操作更方便、快捷;
3、参数高度集成,只需拖拉鼠标或滚动滚轮即可调整参数,可以在图像窗口实时查看当前参数对最终识别效果,简洁、易用,实验人员可以快速上手、掌握实验菌落计数操作;
4、可读取平板计数、螺旋接种、涂布法、倾注法、网格滤膜等菌落数;
5、更多产品特性请前往环凯官网(huankai.com)了解。
文章来源网络,转载只为分享目的,如有侵权请联系删除,谢谢!







